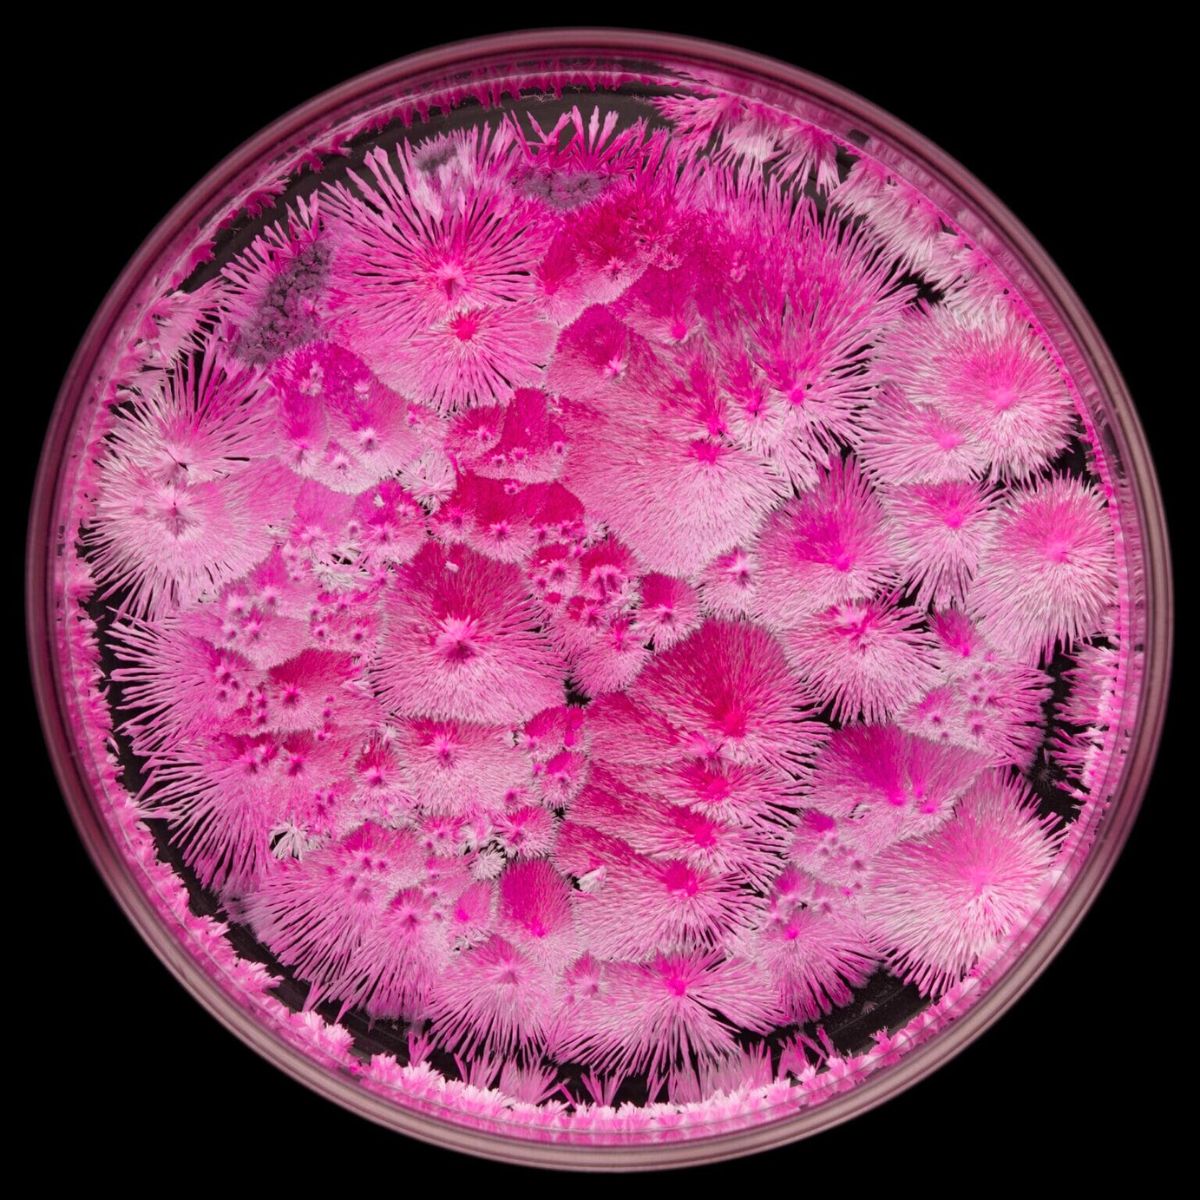
Bright pink crystalization

Wenting Zhu and the team at Beauty of Science have released another visual ode to nature's processes. 'Crystal Garden: Seasons' combines organic compounds and pigments to create a kaleidoscope of colorful growths that spring up and crawl across the tiny, round vessels. The result? Something amazingly colorful. Tune in to see more.
Crystal Garden: Seasons by Wenting Zhu and Beauty of Science
There's something disruptive about watching crystals form. Not the typical polished, cut shapes displayed on velvet in jewelry shops, but the way crystals arrange themselves when they grow under their own unseen forces. This is the ground that Wenting Zhu chose to explore in Crystal Garden: Seasons, a new visual project released by Beauty of Science that brought hundreds of small, round vessels into a single frame and watched as chemical compounds began to take shape under controlled conditions. What unfolds on screen has none of the predictability of conventional nature footage, yet it feels as though something very close to nature's own logic is at work.
The premise is elegantly simple: more than 100 tiny petri dishes are filled with distinct chemical mixtures, each one prepared to invite crystallization. Pigments interact with these compounds, and the results creep, crackle, fold, and unfurl across the glass surfaces with movement and agency, as though microscopic life forms were exploring the confines of their transparent worlds. This is nature invited inside a frame, shaking hands with the deliberate and often strange forces of human intervention. Crystals layering like branches and leaves, blooming like clustered flowers. Dense crystalline formations conjure seasonal landscapes.
Small Dishes, Entire Landscapes
In a short description of the work, Zhu wrote that the idea of a garden serves as a metaphor for the meeting of the natural and the man-made. A garden, by definition, is both intentional and wild - a place where human design encounters ecological unpredictability. In this series, those dual impulses seem to negotiate on a tiny stage. A pattern here might resemble coral weaving against a tide; another caresses its boundaries like frost sprawled across a windowpane at dawn. These crystalline forms seem both alien and familiar at once, resisting easy categorization while still echoing patterns we recognize from leaves, petals, and the weathered stones of rock gardens.
What makes Crystal Garden: Seasons especially compelling is the way it foregrounds processes that usually go unnoticed. Crystallization is a chemical event, yet when presented this visually - enlarged, arranged, and sequenced - it becomes something almost cinematic. The growth has texture, a kind of choreography; it refuses to be static. The tiny dishes, each like its own world, begin to look like a sprawling landscape seen from above, as though a drone had descended into a landscape too small to be seen with the naked eye.
Between Formula and Form
This project also invites reflection on how formula and form interact. Scientific visualization usually strives for clarity, for representation that serves an explanatory purpose. Zhu's work, by contrast, focuses less on conveying information and more on what happens when materials are coaxed into exhibiting their inherent tendencies.

In doing so, the boundaries between scientific documentation and artistic expression become permeable. The visual outcome asks viewers to reconsider what a 'garden' can be, and how much agency we assign to natural systems versus the human frameworks we impose upon them.
Photos: Beauty of Science.